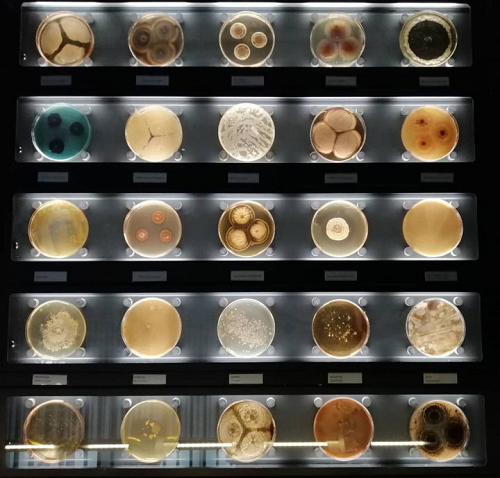
Biovision品牌常見傳染病檢測工具

AGENT BRAND
品牌專題
傳染病〔Infectious Diseases〕是由各種病原體引起的能在人與人、動物與動物或人與動物之間相互傳播的一類疾病。病原體中大部分是微生物,小部分為寄生蟲,寄生蟲引起者又稱寄生蟲病。
根據(jù)國家傳染病防治法規(guī)定管理的傳染病分甲類、乙類、丙類三類。
甲類2種:鼠疫,霍亂。
乙類26種:傳染性非典型肺炎、艾滋病、病毒性肝炎、脊髓灰質(zhì)炎、人感染高致病性禽流感、麻疹、流行性出血熱、狂犬病、流行性乙型腦炎、登革熱、炭疽、細(xì)菌性和阿米巴性痢疾、肺結(jié)核、傷寒和副傷寒、流行性腦脊髓膜炎、百日咳、白喉、新生兒破傷風(fēng)、猩紅熱、布魯氏菌病、淋病、梅毒、鉤端螺旋體病、血吸蟲病、瘧疾、甲型H1N1流感(原稱人感染豬流感)。
丙類11種:血吸蟲病、絲蟲病、包蟲病、麻風(fēng)病、流行性感冒、流行性腮腺炎、流行性和地方性斑疹傷寒、風(fēng)疹、急性出血性結(jié)膜炎、手足口病,以及除霍亂、阿米巴痢疾、傷寒和副傷寒以外的感染性腹瀉病傳染病。
下面介紹幾種影響最深遠(yuǎn)以及跟我們生活密切相關(guān)的傳染病:
1、天花(smallpox,variola)它是天花病毒引起的烈性傳染病,死亡率很高。
2、鼠疫(又名黑死病)因患者的皮膚上會出許多黑斑而得名黑死病,
3、霍亂因,因動蕩的社會秩序、沒有清潔的飲用水、缺醫(yī)少藥,成為霍亂流行的最主要因素。
4、艾滋病(AIDS)目前我國的艾滋病流行也進(jìn)入了高速增長期,最保守的估計也已經(jīng)有84萬艾滋病病毒感染者,并以每年30%的速度遞增。
| 產(chǎn)品名稱 | 規(guī)格 | 貨號 |
| HIV-1蛋白酶活性測定試劑盒(熒光法) | 100 tests | K825 |
| HIV-2蛋白酶活性測定試劑盒(熒光法) | 100 tests | K845 |
| HIV-1蛋白酶抑制劑篩選試劑盒(熒光法) | 100 tests | K826 |
| 活性HIV1蛋白酶重組體(GST標(biāo)簽) | 100ug | 7849 |
| 活性HIV-2蛋白酶重組體(帶GST標(biāo)簽) | 100ug | 7851 |
| 抗HIV / p24抗體(1D4) | 100ug | A1020 |
5.登革熱(Dengue)1999年首次在美國暴發(fā)以來,西尼羅熱已持續(xù)5年在美國流行,流行規(guī)模越來越大,并且繼續(xù)向中美和南美國家蔓延。目前我國尚沒有感染西尼羅病毒的病例報告
| 產(chǎn)品名稱 | 規(guī)格 | 貨號 |
| 登革熱IgM ELISA試劑盒 | 100 tests | E4671 |
| 登革熱IgG ELISA試劑盒 | 100 tests | E4670 |
6.非典(SARS)――呼吸道傳染病肆虐 2003年在全球引起最大影響的莫過于新發(fā)現(xiàn)的嚴(yán)重急性呼吸綜合征(SARS)。是當(dāng)年中國研究非常透徹的一個病毒,它是通過與人的ACE2蛋白互作結(jié)合進(jìn)入人體的。
| 產(chǎn)品名稱 | 規(guī)格 | 貨號 |
| 血管緊張素II轉(zhuǎn)換酶(ACE2)活性測定試劑盒(熒光法) | 100 tests | K897 |
| 血管緊張素II轉(zhuǎn)換酶(ACE2)抑制劑篩選試劑盒 | 100 tests | K310 |
7.埃博拉病毒(Ebola) 感染埃博拉病毒的患者病死率達(dá)到50%~90%。患者死亡時器官溶解,全身毛孔和腔道出血,死狀恐怖。故該病毒被認(rèn)為是一種潛在的生物武器。
| 埃博拉病毒檢測試劑盒 | 348361、348437 |
| 篇幅有限更多歡迎咨詢我們 | |
8.布魯氏菌病: 布魯氏菌病是由布魯氏菌引起的,人畜共患的疾病(以下簡稱布病)!在我國屬于乙類傳染病,就跟我們熟知的瘧疾、肺結(jié)核、艾滋病屬于同一類傳染病。
| 產(chǎn)品名稱 | 規(guī)格 | 貨號 |
| 布魯氏菌IgM ELISA試劑盒 | 100 tests | E4710 |
| 布魯氏菌IgG ELISA試劑盒 | 100 tests | E4709 |
| 產(chǎn)品名稱 | 一般產(chǎn)量 | 樣品類型 |
| PEG病毒沉淀試劑盒(K904) | 濃縮至100倍 | 細(xì)胞培養(yǎng)基或環(huán)境樣品中的逆轉(zhuǎn)錄病毒,桿狀病毒,慢病毒,噬菌體等 |
微信掃碼在線客服